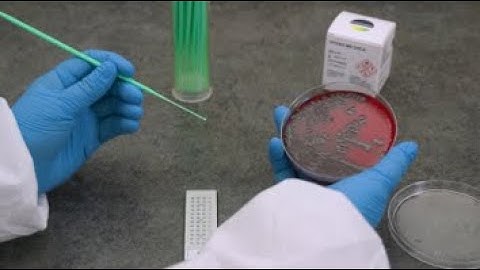
VITEK MS: Sample Prep - Bacteria/Yeast Using a Loop

⬇ DOWNLOAD NOW
Kalau muncul iklan pop-up, tutup lalu klik tombol kembali
Download lagu VITEK MS: Sample Prep-Mycobacteria Liquid secara gratis hanya untuk keperluan promosi. Dukung artis favorit kamu dengan membeli musik original di iTunes atau platform resmi lainnya.
 VITEK MS: Sample Prep-Mycobacteria and Nocardia
VITEK MS: Sample Prep-Mycobacteria and Nocardia
VITEK MS: Sample Prep - Bacteria/Yeast Using a Loop
VITEK MS: Sample Prep - Bacteria/Yeast Using a Loop
 MALDI TOF Process
MALDI TOF Process
 VITEK FLEXPREP for VITEK MS and VITEK 2
VITEK FLEXPREP for VITEK MS and VITEK 2
 VITEK MS: Prep Station Entering VITEK 2 Test Cards
VITEK MS: Prep Station Entering VITEK 2 Test Cards
 Mycobacterium Tuberculosis Replication
Mycobacterium Tuberculosis Replication
 VITEK MS: Acquisition Station Running a Target Slide
VITEK MS: Acquisition Station Running a Target Slide
 Mycobacteria
Mycobacteria